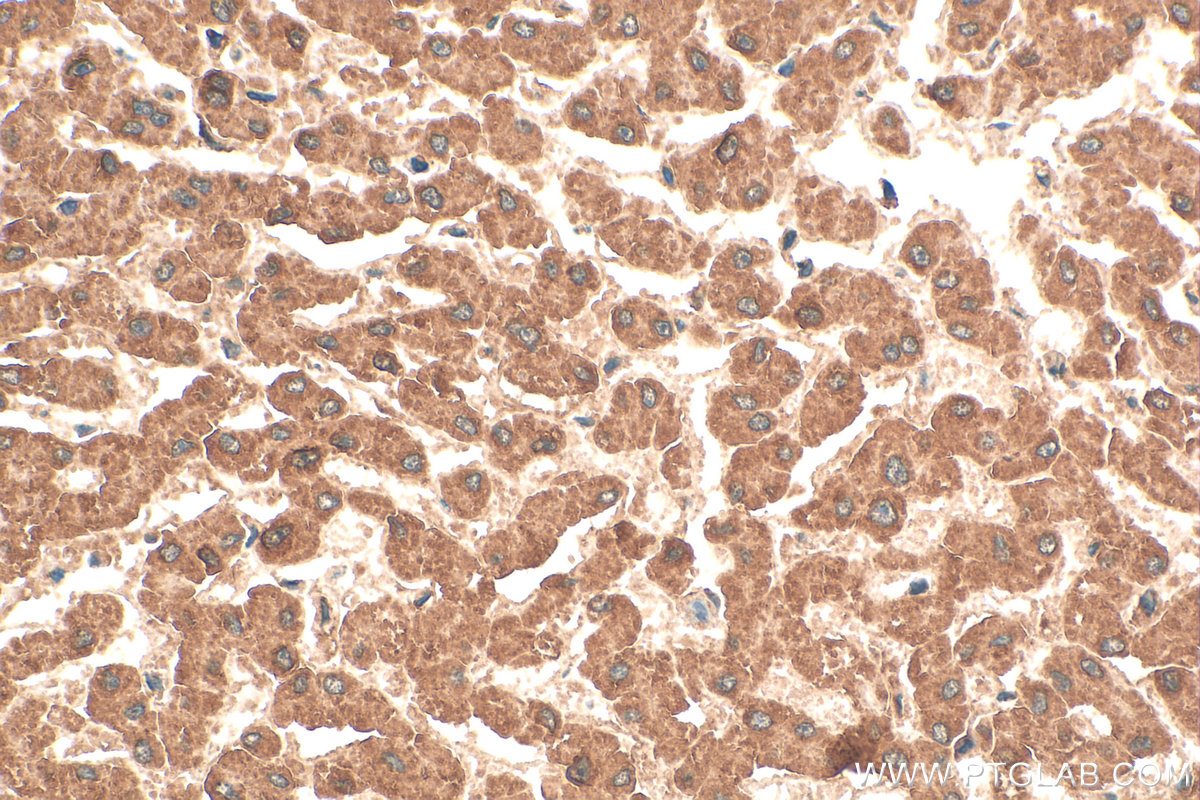
Immunohistochemical analysis of paraffin-embedded human liver tissue slide using 21566-1-AP (NAGS antibody) at dilution of 1:200 (under 40x lens). Heat mediated antigen retrieval with Tris-EDTA buffer (pH 9.0). IHC staining of human liver using 21566-1-AP

验证数据展示
经过测试的应用
| Positive WB detected in | mouse liver tissue, Jurkat cells, HepG2 cells, L02 cells, rat liver tissue |
| Positive IHC detected in | human liver tissue, human small intestine tissue Note: suggested antigen retrieval with TE buffer pH 9.0; (*) Alternatively, antigen retrieval may be performed with citrate buffer pH 6.0 |
推荐稀释比
| 应用 | 推荐稀释比 |
|---|---|
| Western Blot (WB) | WB : 1:1000-1:6000 |
| Immunohistochemistry (IHC) | IHC : 1:50-1:500 |
| It is recommended that this reagent should be titrated in each testing system to obtain optimal results. | |
| Sample-dependent, Check data in validation data gallery. | |
发表文章中的应用
| WB | See 3 publications below |
| IHC | See 1 publications below |
产品信息
21566-1-AP targets NAGS in WB, IHC, ELISA applications and shows reactivity with human, mouse, rat samples.
| 经测试应用 | WB, IHC, ELISA Application Description |
| 文献引用应用 | WB, IHC |
| 经测试反应性 | human, mouse, rat |
| 文献引用反应性 | human, mouse, rat |
| 免疫原 |
CatNo: Ag16073 Product name: Recombinant human NAGS protein Source: e coli.-derived, PGEX-4T Tag: GST Domain: 1-368 aa of BC111713 Sequence: MDMKPLVVLGLPAPTAPSGCLSFWEAKAQLAKSCKVLVDALRHNAAAAVPFFGGGSVLRAAEPAPHASYGGIVSVETDLLQWCLESGSIPILCPIGETAARRSVLLDSLEVTASLAKALRPTKIIFLNNTGGLRDSSHKVLSNVNLPADLDLVCNAEWVSTKERQQMRLIVDVLSRLPHHSSAVITAASTLLTELFSNKGSGTLFKNAERMLRVRSLDKLDQGRLVDLVNASFGKKLRDDYLASLRPRLHSIYVSEGYNAAAILTMEPVLGGTPYLDKFVVSSSRQGQGSGQMLWECLRRDLQTLFWRSRVTNPINPWYFKHSDGSFSNKQWIFFWFGLADIRDSYELVNHAKGLPDSFHKPASDPGS 种属同源性预测 |
| 宿主/亚型 | Rabbit / IgG |
| 抗体类别 | Polyclonal |
| 产品类型 | Antibody |
| 全称 | N-acetylglutamate synthase |
| 别名 | AGAS, Amino-acid acetyltransferase, ARGA, EC:2.3.1.1, N-acetylglutamate synthase conserved domain form |
| 计算分子量 | 534 aa, 58 kDa |
| 观测分子量 | 58-66 kDa |
| GenBank蛋白编号 | BC111713 |
| 基因名称 | NAGS |
| Gene ID (NCBI) | 162417 |
| RRID | AB_10733886 |
| 偶联类型 | Unconjugated |
| 形式 | Liquid |
| 纯化方式 | Antigen affinity purification |
| UNIPROT ID | Q8N159 |
| 储存缓冲液 | PBS with 0.02% sodium azide and 50% glycerol, pH 7.3. |
| 储存条件 | Store at -20°C. Stable for one year after shipment. Aliquoting is unnecessary for -20oC storage. |
背景介绍
N-acetylglutamate synthase, also known as NAGS, is a mitochondrial enzyme that catalyzes the formation of N-acetylglutamate (NAG) from glutamate and acetyl coenzyme-A. NAGS is the key enzyme for regulating the hepatic urea cycle and is also highly expressed in the kidney and gut. Deficiency of NAGS leads to hyperammonemia due to decreased activity of CPSI deprived of its cofactor NAG(PMID:12459178,12754705).
实验方案
| Product Specific Protocols | |
|---|---|
| IHC protocol for NAGS antibody 21566-1-AP | Download protocol |
| WB protocol for NAGS antibody 21566-1-AP | Download protocol |
| Standard Protocols | |
|---|---|
| Click here to view our Standard Protocols |
发表文章
| Species | Application | Title |
|---|---|---|
Mol Metab SWI/SNF complex subunit BAF60a represses hepatic ureagenesis through a crosstalk between YB-1 and PGC-1α. | ||
Heliyon Machine learning deciphers the significance of mitochondrial regulators on the diagnosis and subtype classification in non-alcoholic fatty liver disease | ||
Drug Des Devel Ther The Potential Mechanisms of Althaea rosea (Linn.) Cavan. Flower in Alleviating Tetrodotoxin Poisoning: An Integrated Metabolomics, Network Pharmacology and Experimental Validation |